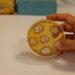
Identifican un mecanismo necesario para que las plantas hagan un mejor uso de los nutrientes

El comisario de Policía Nacional de Torremolinos-Benalmádena, Antonio De Haro, acompañado del concejal de Comercio, Raúl Campos, el jefe de Policía Local, Juan Carlos Merchán, y la presidenta de ACEB, Rosa María González Rubia, ha visitado la sede de la Asociación de Comerciantes y Empresarios de Benalmádena (ACEB) y de la Asociación Centro Comercial Abierto de Benalmádena (ACCAB), para presentar la campaña nacional de Policía ‘Comercio Seguro’, que se activa cada año en estas fechas con el objeto de potenciar la seguridad en el sector comercial, tanto físico como online, durante la campaña de Navidad.
La campaña ‘Comercio Seguro’ incluye en su fase preventiva la difusión de una guía práctica con recomendaciones para que los establecimientos y ciudadanos estén prevenidos ante el aumento de visitas a los comercios durante la campaña navideña, y ante posibles fraudes en las compras online.
En esta fase, se están realizando diferentes contactos con los comerciantes y colectivos para aportarles consejos útiles sobre seguridad, tales como la seguridad en los medios de pago, la detección de billetes falsos, o extremar la precaución en momentos de mayor afluencia de público.
De Haro ha reiterado un año más la necesaria colaboración de los comerciantes y ciudadanos, “llamando al 091 para alertar si detectan hurtos o situaciones sospechosas” y ha recordado la dirección web donde se pueden consultar otros consejos de interés, www.policia.es.
Por su parte, el concejal de Comercio ha destacado “la estrecha colaboración y coordinación existente entre ambos cuerpos policiales”, toda vez que ha animado a los ciudadanos a realizar sus compras en el comercio local de proximidad y recordado las numerosas medidas que ha impulsado el Consistorio para impulsar esas compras, como la apertura del aparcamiento de Pueblosol a un euro al día en horario comercial.
FInalmente, la presidenta de ACEB ha agradecido la visita del comisario, recordando la colaboración que se presta desde la asociación en la divulgación de las medidas preventivas que incluye esta campaña, “especialmente en la época del año que registra el mayor flujo de ventas comerciales”.